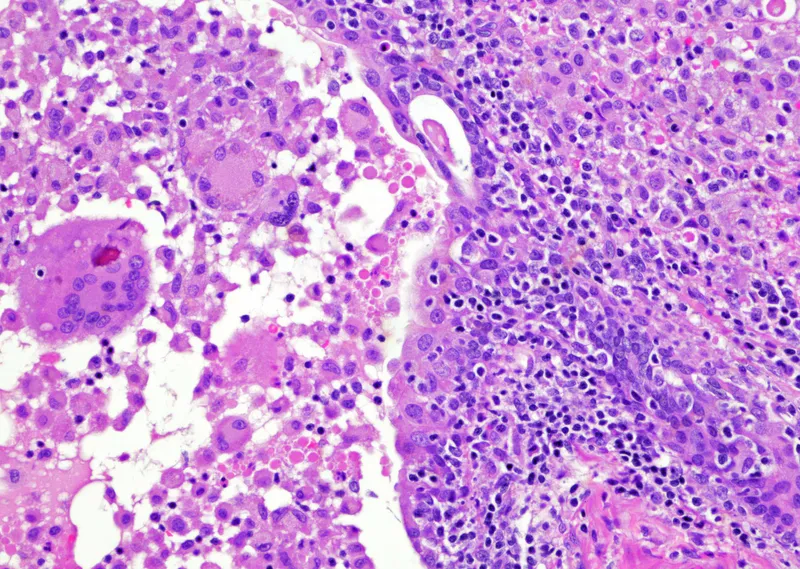
Granulomatous prostatitis with giant cells

Prostate Anatomy & Histo - Gland Essentials
- Zones: Key anatomical regions.
- Peripheral Zone (PZ): Largest, posterior.
- Central Zone (CZ): Surrounds ejaculatory ducts.
- Transitional Zone (TZ): Surrounds urethra; site of BPH.
- 📌 Mnemonic: "Pee Cee Tee" (Peripheral, Central, Transitional).
- Epithelial Cells: Comprises basal, luminal, and neuroendocrine types.
- Basal cells: Outer layer; p63+, HMWCK+.
- Luminal (secretory) cells: Inner layer; PSA+, PAP+.
- Neuroendocrine cells: Scattered; chromogranin A+.
- Corpora Amylacea: Eosinophilic, laminated concretions in acini; ↑ with age.

⭐ The peripheral zone is the most common site for prostate cancer (approx. 70%).
Prostatitis - Inflamed Gland
Inflammation of the prostate gland, categorized by etiology and clinical presentation.
| Type | Etiology | Key Clinical Features | Histology |
|---|---|---|---|
| Acute Bacterial | E. coli (most common), other gram-negatives | Fever, chills, dysuria, tender, boggy prostate | Neutrophils in glands, stromal edema, hyperemia |
| Chronic Bacterial | Recurrent UTIs, E. coli | Recurrent bacteriuria, pelvic/perineal pain, dysuria | Lymphocytes, plasma cells, macrophages |
| Chronic Abacterial / CPPS | Unknown (most common type) | Pelvic pain >3 months, voiding symptoms, no uropathogen | Lymphocytes, may be normal |
| Granulomatous | Post-BCG therapy, post-TURP, fungal, idiopathic | Variable; may mimic carcinoma | Epithelioid granulomas, giant cells, lymphocytes |
BPH & PIN - Benign Growths
- Benign Prostatic Hyperplasia (BPH):
- Common in older men; Dihydrotestosterone (DHT)-driven.
- Zone: Transitional.
- Histo: Nodular stromal & glandular hyperplasia.
- Clinical: Lower Urinary Tract Symptoms (LUTS) (nocturia, weak stream), smooth firm enlarged prostate.
- Complications: UTI, hydronephrosis, retention, calculi.
- Prostatic Intraepithelial Neoplasia (PIN):
- High-Grade PIN (HGPIN) is precursor to prostate adenocarcinoma.
- Zone: Peripheral (typically).
- Histo: Cytological atypia (prominent nucleoli, nuclear hyperchromasia), intact basal cell layer (p63+).
Comparison: BPH vs HGPIN
| Feature | BPH | HGPIN |
|---|---|---|
| Zone | Transitional (periurethral) | Peripheral (predominantly) |
| Pathogenesis | DHT-driven hyperplasia (stroma, glands) | Precursor to cancer; atypia |
| Key Histo | Nodular hyperplasia (glands, stroma) | Atypia, prominent nucleoli, intact basal cells (p63+) |
| Clinical Signif. | LUTS, obstruction, complications | ↑ Cancer risk; surveillance |
⭐ Benign Prostatic Hyperplasia (BPH) characteristically arises in the transitional zone of the prostate.
Prostate Cancer - Malignant Threat
- Type & Location: Adenocarcinoma, most common prostatic cancer; typically arises in peripheral zone.
- Key Risk Factors: Advanced age (↑Age), African-American race, positive family history (BRCA2 mutations).
- PSA:
- Serum >4 ng/mL suspicious.
- Also ↑ in BPH/prostatitis.
- ↓free/total PSA ratio (<0.15) more indicative of cancer.
- Gleason Score:
- Architectural patterns 1-5 (well to poorly differentiated).
- Sum of 2 most common (e.g., 3+4=7).
- Higher score = worse prognosis.
- Histopathology: Perineural invasion is a common finding and hallmark of malignancy.
- Metastasis: Osteoblastic (bone-forming) metastases, often to lumbar vertebrae. 📌 Prostate = Produces Bone.
⭐ Prostate cancer typically causes osteoblastic (bone-forming) metastases, particularly to the lumbar spine.

High‑Yield Points - ⚡ Biggest Takeaways
- Prostatic Intraepithelial Neoplasia (PIN) is a significant precursor to prostate adenocarcinoma.
- The Gleason score is crucial for grading prostate adenocarcinoma, impacting prognosis and treatment.
- Prostate cancer most commonly arises in the peripheral zone of the prostate.
- PSA (Prostate-Specific Antigen) is a valuable tumor marker, though not specific for cancer.
- Benign Prostatic Hyperplasia (BPH) typically affects the transitional zone, leading to urinary obstruction.
- Prostate cancer frequently metastasizes to bone, characteristically forming osteoblastic lesions.
Unlock the full lesson and continue reading
Signup to continue reading this lesson and unlimited access questions, flashcards, AI notes, and more